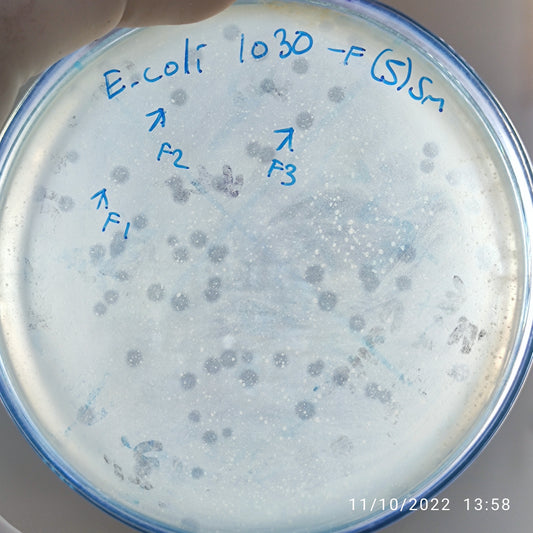
Escherichia coli bacteriophage 101030F
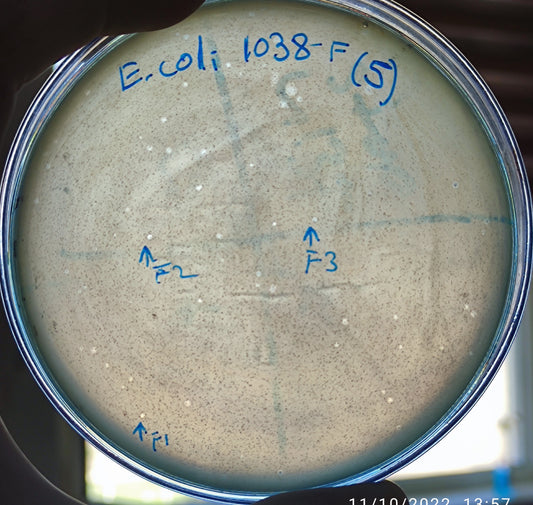
Escherichia coli bacteriophage 101038F
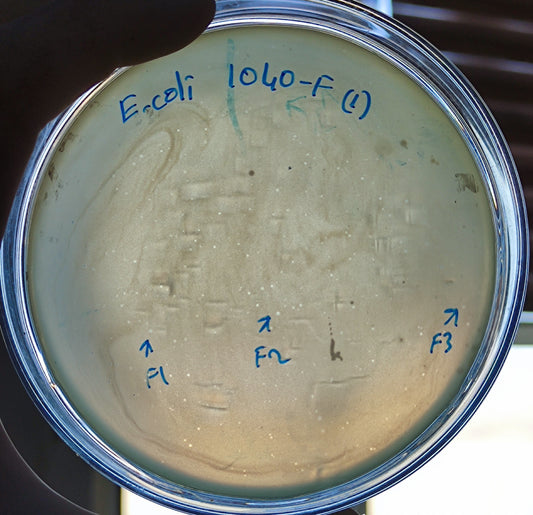
Escherichia coli bacteriophage 101040F
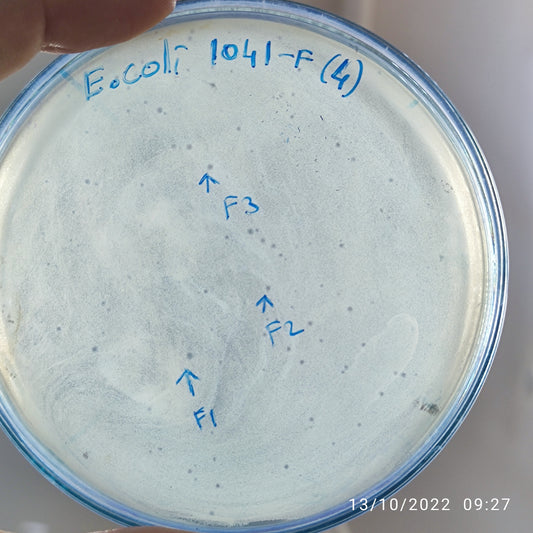
Escherichia coli bacteriophage 101041F
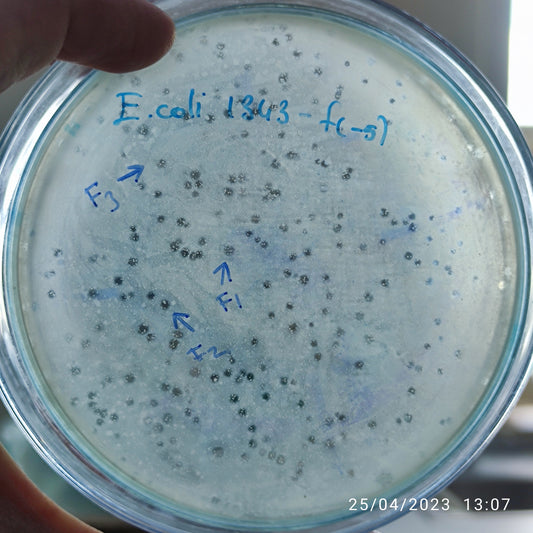
Escherichia coli bacteriophage 101043F
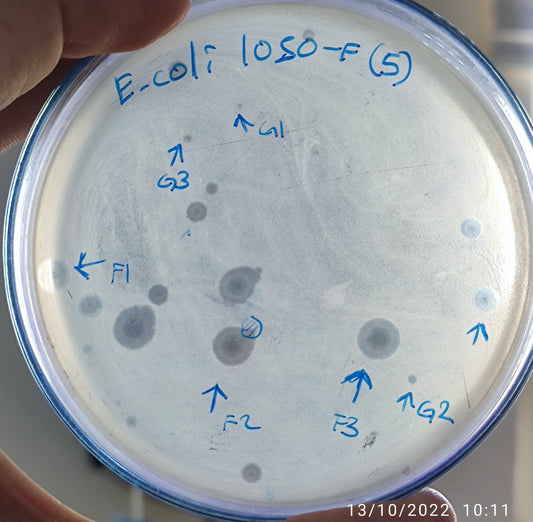
Escherichia coli bacteriophage 101050F
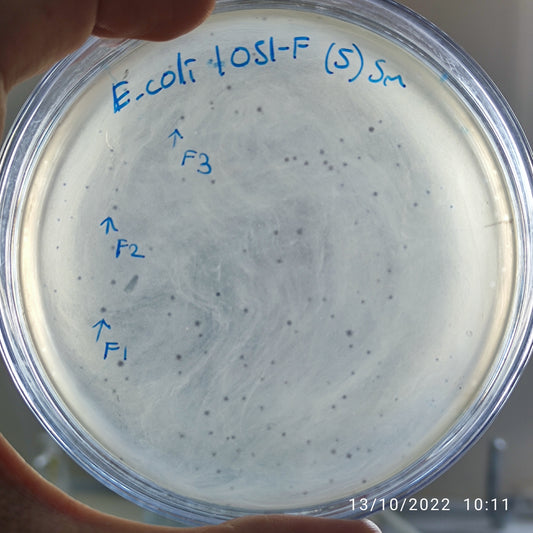
Escherichia coli bacteriophage 101051F
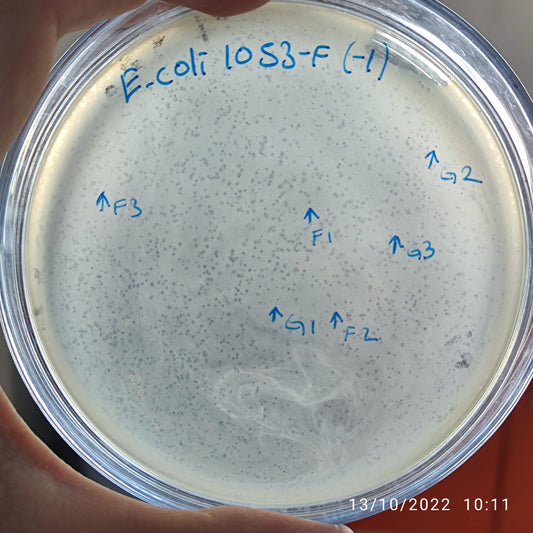
Escherichia coli bacteriophage 101053F
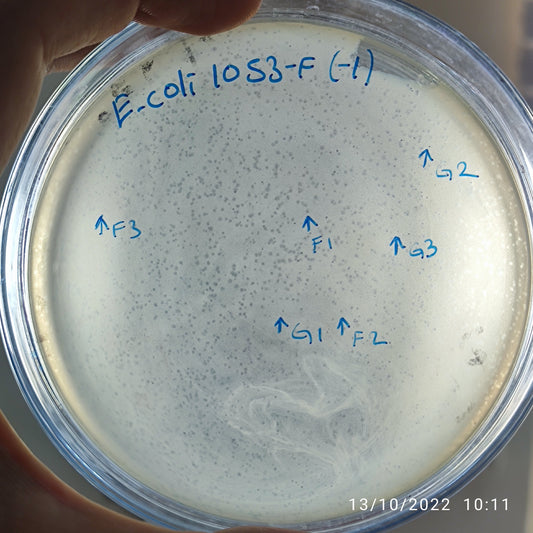
Escherichia coli bacteriophage 101053G
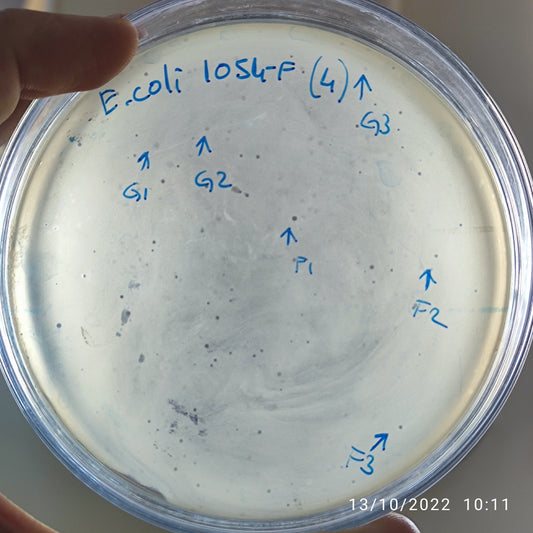
Escherichia coli bacteriophage 101054G
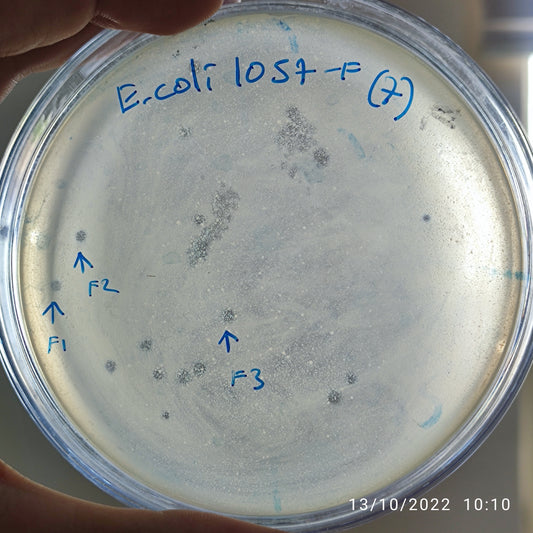
Escherichia coli bacteriophage 101057F

-
Escherichia coli bacteriophage 101030F
Regular price $800.00 USDRegular priceUnit price per -
Escherichia coli bacteriophage 101038F
Regular price $700.00 USDRegular priceUnit price per -
Escherichia coli bacteriophage 101040F
Regular price $750.00 USDRegular priceUnit price per -
Escherichia coli bacteriophage 101041F
Regular price $500.00 USDRegular priceUnit price per -
Escherichia coli bacteriophage 101042F
Regular price $650.00 USDRegular priceUnit price per -
Escherichia coli bacteriophage 101043F
Regular price $900.00 USDRegular priceUnit price per -
Escherichia coli bacteriophage 101047F
Regular price $650.00 USDRegular priceUnit price per -
Escherichia coli bacteriophage 101050F
Regular price $900.00 USDRegular priceUnit price per -
Escherichia coli bacteriophage 101050G
Regular price $500.00 USDRegular priceUnit price per -
Escherichia coli bacteriophage 101051F
Regular price $650.00 USDRegular priceUnit price per -
Escherichia coli bacteriophage 101053F
Regular price $650.00 USDRegular priceUnit price per -
Escherichia coli bacteriophage 101053G
Regular price $500.00 USDRegular priceUnit price per -
Escherichia coli bacteriophage 101054F
Regular price $700.00 USDRegular priceUnit price per -
Escherichia coli bacteriophage 101054G
Regular price $600.00 USDRegular priceUnit price per -
Escherichia coli bacteriophage 101056F
Regular price $650.00 USDRegular priceUnit price per -
Escherichia coli bacteriophage 101057F
Regular price $750.00 USDRegular priceUnit price per